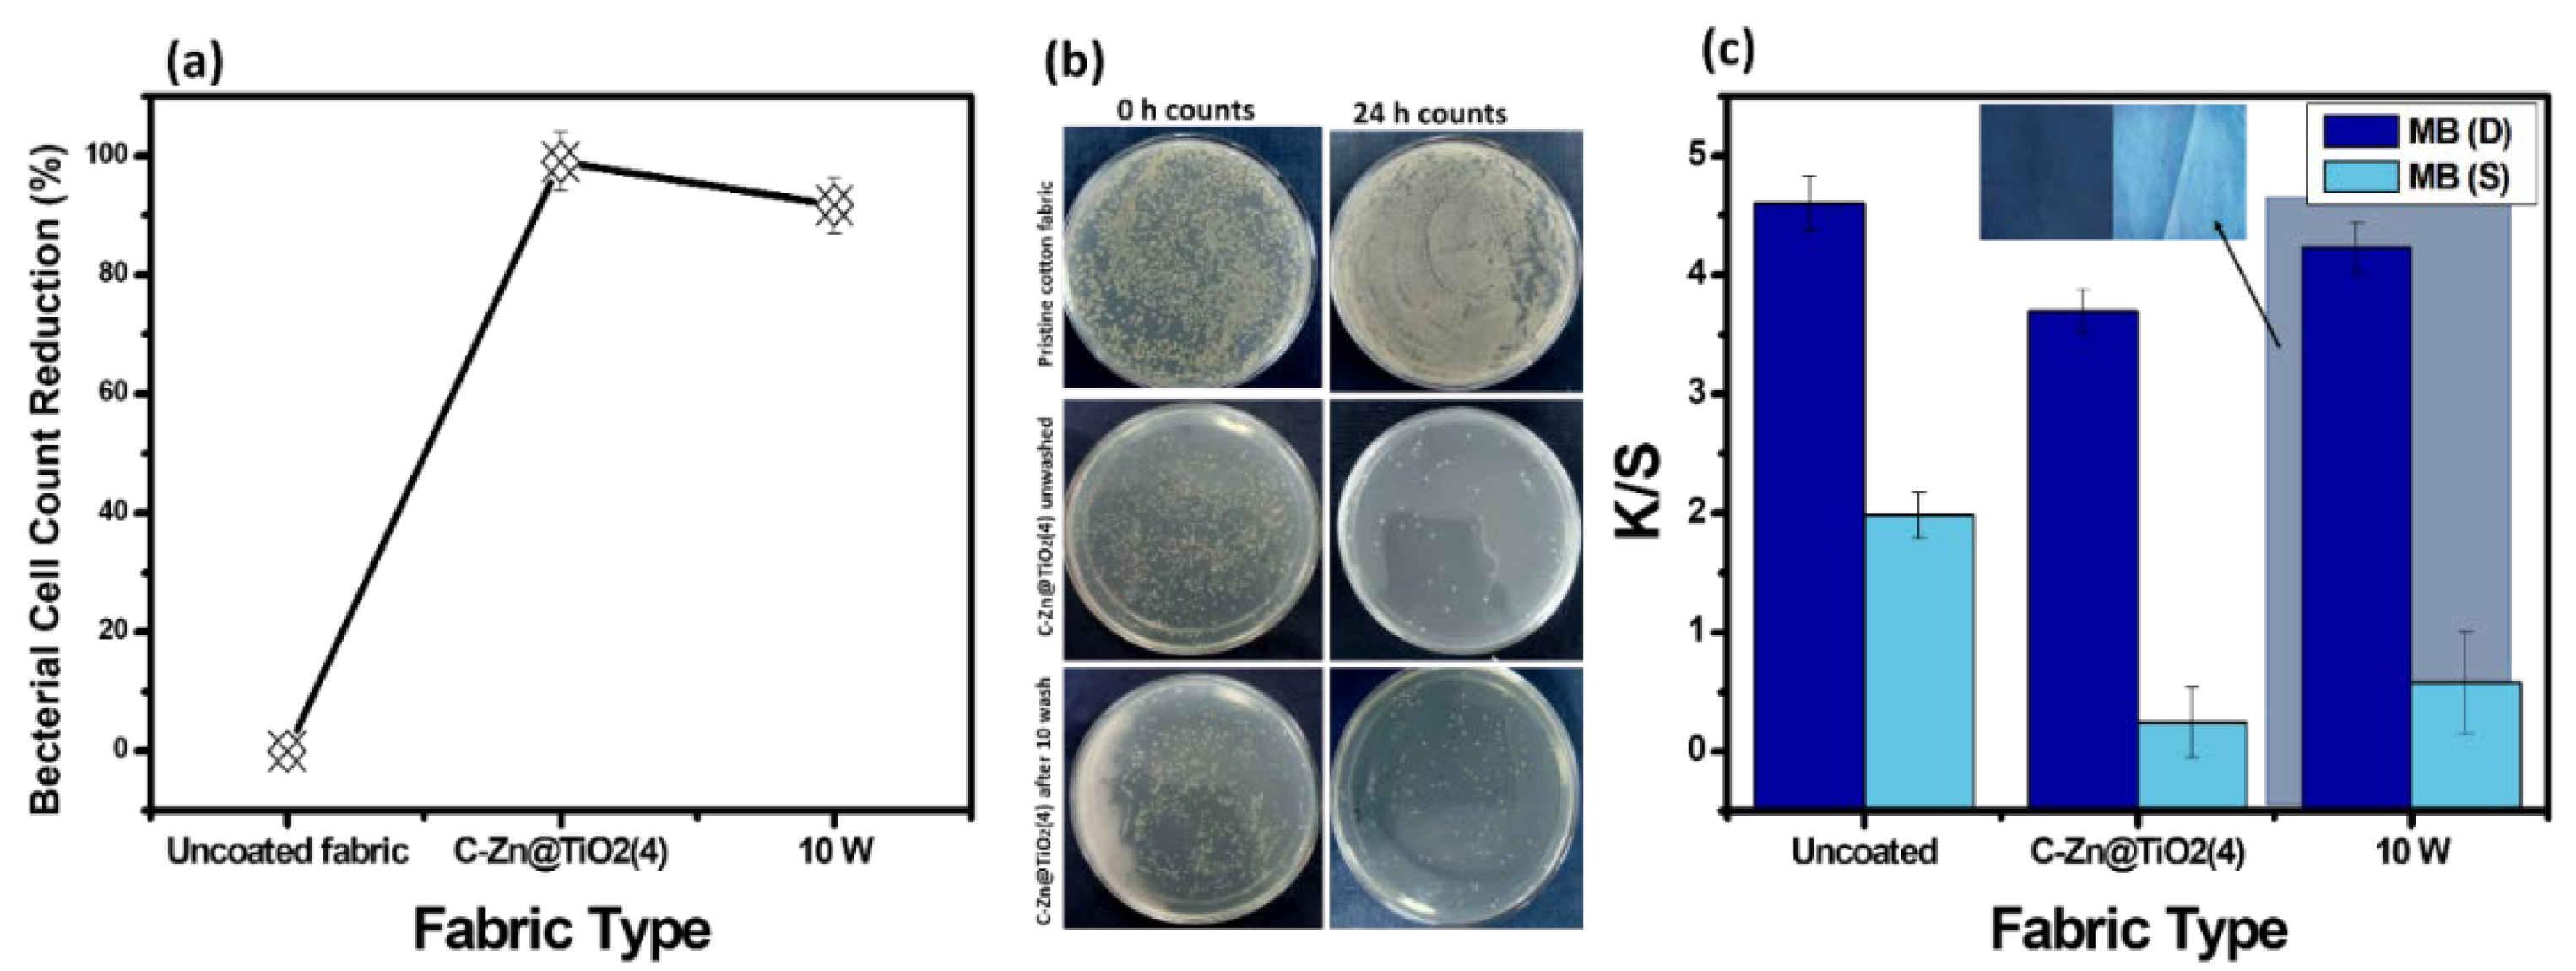
Polymers 15 02775 g011

Sunlight-Driven Photocatalytic Active Fabrics through Immobilization of Functionalized Doped Titania Nanoparticles
Abstract
1. Introduction
2. Materials and Methods
2.1. Chemicals and Materials
2.2. Synthesis of NPs and Immobilization on Fabric
2.2.1. Synthesis of TiO2 NPs
2.2.2. Synthesis of Zn@TiO2 NPs
2.2.3. Functionalization of Pristine TiO2 and Zn@TiO2 NPs Using GPTS
2.2.4. Immobilization of Pristine TiO2 and Zn@TiO2 NPs on Fabric
2.3. Testing and Characterization
2.4. Photocatalytic Activity Test
2.5. K/S (Color Strength) Analysis
2.6. Kinetic Study
3. Results and Discussions
3.1. Characterization
3.2. Photocatalytic Degradation Experimentation
3.3. K/S (Color Strength)
3.4. Radical Trapping Experiment and Proposed Dye Degradation Mechanism
3.5. Sunlight-Assisted Degradation Potential of Functionalized Zn@TiO2 NPs Immobilized on Cotton Substrate against Dispersed Coraline Yellow, Orange, and Red Dyes: The Sublimizable Pollutants
3.6. A Kinetic Study Using Zn@TiO2-0.5 against MB and MO Dyes
3.7. Antibacterial Activity Analysis and Washing Durability Test
3.8. Comfort Properties
Air Permeability Water Permeability
4. Conclusions
Author Contributions
Funding
Institutional Review Board Statement
Informed Consent Statement
Data Availability Statement
Acknowledgments
Conflicts of Interest
References
- Wang, J.; Zhao, J.; Sun, L.; Wang, X. A review on the application of photocatalytic materials on textiles. Text. Res. J. 2015, 85, 1104–1118. [Google Scholar] [CrossRef]
- Hassan, F.M.; Al-Obaidy, A.M.J.; Al-Ani, R.R. Detection of detergents (surfactants) in Tigris River-Baghdad Iraq. IJEW 2017, 6, 1–15. [Google Scholar]
- Alotaibi, M.T.; Mogharbel, R.T.; Alorabi, A.Q.; Alamrani, N.A.; Shahat, A.; El-Metwaly, N.M. Superior adsorption and removal of toxic industrial dyes using cubic Pm3n aluminosilica form an aqueous solution, Isotherm, Kinetic, thermodynamic and mechanism of interaction. J. Mol. Liq. 2023, 379, 121672. [Google Scholar] [CrossRef]
- Fatima, N.; Qazi, U.Y.; Mansha, A.; Bhatti, I.A.; Javaid, R.; Abbas, Q.; Nadeem, N.; Rehan, Z.A.; Noreen, S.; Zahid, M. Recent developments for antimicrobial applications of graphene-based polymeric composites: A review. J. Ind. Eng. Chem. 2021, 100, 40–58. [Google Scholar] [CrossRef]
- Ragusa, A.; Notarstefano, V.; Svelato, A.; Belloni, A.; Gioacchini, G.; Blondeel, C.; Zucchelli, E.; De Luca, C.; D’avino, S.; Gulotta, A.; et al. Raman Microspectroscopy Detection and Characterisation of Microplastics in Human Breastmilk. Polymers 2022, 14, 2700. [Google Scholar] [CrossRef] [PubMed]
- Daoud, W.A.; Xin, J.H. Nucleation and growth of anatase crystallites on cotton fabrics at low temperatures. J. Am. Ceram. Soc. 2004, 87, 953–955. [Google Scholar] [CrossRef]
- Jiang, X.; Tian, X.; Gu, J.; Huang, D.; Yang, Y. Cotton fabric coated with nano TiO2-acrylate copolymer for photocatalytic self-cleaning by in-situ suspension polymerization. Appl. Surf. Sci. 2011, 257, 8451–8456. [Google Scholar] [CrossRef]
- Samokhvalov, A. Hydrogen by photocatalysis with nitrogen codoped titanium dioxide. Renew. Sustain. Energy Rev. 2017, 72, 981–1000. [Google Scholar] [CrossRef]
- Bakbolat, B.; Daulbayev, C.; Sultanov, F.; Beissenov, R.; Umirzakov, A.; Mereke, A.; Bekbaev, A.; Chuprakov, I. Recent developments of TiO2-based photocatalysis in the hydrogen evolution and photodegradation: A review. Nanomaterials 2020, 10, 1790. [Google Scholar] [CrossRef]
- Yin, S.; Zhang, Q.; Saito, F.; Sato, T. Preparation of visible light-activated titania photocatalyst by mechanochemical method. Chem. Lett. 2003, 32, 358–359. [Google Scholar] [CrossRef]
- Gao, B.; Yap, P.S.; Lim, T.M.; Lim, T.-T. Adsorption-photocatalytic degradation of Acid Red 88 by supported TiO2: Effect of activated carbon support and aqueous anions. Chem. Eng. J. 2011, 171, 1098–1107. [Google Scholar] [CrossRef]
- Mallakpour, S.; Nikkhoo, E. Surface modification of nano-TiO2 with trimellitylimido-amino acid-based diacids for preventing aggregation of nanoparticles. Adv. Powder Technol. 2014, 25, 348–353. [Google Scholar] [CrossRef]
- Minero, C.; Vione, D. A quantitative evalution of the photocatalytic performance of TiO2 slurries. Appl. Catal. B Environ. 2006, 67, 257–269. [Google Scholar] [CrossRef]
- Bannat, I.; Wessels, K.; Oekermann, T.; Rathousky, J.; Bahnemann, D.; Wark, M. Improving the photocatalytic performance of mesoporous titania films by modification with gold nanostructures. Chem. Mater. 2009, 21, 1645–1653. [Google Scholar] [CrossRef]
- Dong, F.; Guo, S.; Wang, H.; Li, X.; Wu, Z. Enhancement of the visible light photocatalytic activity of C-doped TiO2 nanomaterials prepared by a green synthetic approach. J. Phys. Chem. C 2011, 115, 13285–13292. [Google Scholar] [CrossRef]
- Lightcap, I.V.; Kosel, T.H.; Kamat, P.V. Anchoring semiconductor and metal nanoparticles on a two-dimensional catalyst mat. Storing and shuttling electrons with reduced graphene oxide. Nano Lett. 2010, 10, 577–583. [Google Scholar] [CrossRef]
- Makarova, O.V.; Rajh, T.; Thurnauer, M.C.; Martin, A.; Kemme, P.A.; Cropek, D. Surface modification of TiO2 nanoparticles for photochemical reduction of nitrobenzene. Environ. Sci. Technol. 2000, 34, 4797–4803. [Google Scholar] [CrossRef]
- Gad-Allah, T.A.; Kato, S.; Satokawa, S.; Kojima, T. Role of core diameter and silica content in photocatalytic activity of TiO2/SiO2/Fe3O4 composite. Solid State Sci. 2007, 9, 737–743. [Google Scholar] [CrossRef]
- Tang, Y.; Zhang, G.; Liu, C.; Luo, S.; Xu, X.; Chen, L.; Wang, B. Magnetic TiO2-graphene composite as a high-performance and recyclable platform for efficient photocatalytic removal of herbicides from water. J. Hazard. Mater. 2013, 252, 115–122. [Google Scholar] [CrossRef]
- Karuppasamy, P.; Nisha, N.R.N.; Pugazhendhi, A.; Kandasamy, S.; Pitchaimuthu, S. An investigation of transition metal doped TiO2 photocatalysts for the enhanced photocatalytic decoloration of methylene blue dye under visible light irradiation. J. Environ. Chem. Eng. 2021, 9, 105254. [Google Scholar] [CrossRef]
- Pitchaimuthu, S.; Rajalakshmi, S.; Kannan, N.; Velusamy, P. Enhancement of zinc oxide-mediated solar light decoloration of Acid Yellow 99 dye by addition of β-CD. Appl. Water Sci. 2015, 5, 201–208. [Google Scholar] [CrossRef]
- Huang, J.G.; Pang, S.; Wang, B.; Ma, H.Y.; Zheng, M.Y.; Dong, L.L.; Liu, X.J. Preparation of undoped and Zn-doped TiO2 by sol-gel method with two different procedures and photocatalytic degradation on phenol. Optoelectron. Adv. Mater. -Rapid Commun. 2015, 9, 139–145. [Google Scholar]
- Safdar, F.; Javid, A.; Ashraf, M. Single Step Synthesis and Functionalization of Nano Titania for Development of Multifunctional Cotton Fabrics. Materials 2021, 15, 38. [Google Scholar] [PubMed]
- Tabasum, A.; Bhatti, I.A.; Nadeem, N.; Zahid, M.; Rehan, Z.A.; Hussain, T.; Jilani, A. Degradation of acetamiprid using graphene-oxide-based metal (Mn and Ni) ferrites as Fenton-like photocatalysts. Water Sci. Technol. 2020, 81, 178–189. [Google Scholar] [PubMed]
- Nadeem, N.; Zahid, M.; Bhatti, H.N.; Shahid, I.; Mustafa, G.; Tabasum, A. Wastewater Remediation Using Coal Fly Ash Nanocomposites. In Aquananotechnology; Elsevier: Amsterdam, The Netherlands, 2021; pp. 149–174. [Google Scholar]
- Nadeem, N.; Zahid, M.; Tabasum, A.; Mansha, A.; Jilani, A.; Bhatti, I.A.; Bhatti, H.N. Degradation of reactive dye using heterogeneous photo-Fenton catalysts: ZnFe2O4 and GO-ZnFe2O4 composite. Mater. Res. Express 2020, 7, 015519. [Google Scholar] [CrossRef]
- Fan, T.; Chen, C.; Tang, Z.; Ni, Y.; Lu, C. Synthesis and characterization of g-C3N4/BiFeO3 composites with an enhanced visible light photocatalytic activity. Mater. Sci. Semicond. Process. 2015, 40, 439–445. [Google Scholar] [CrossRef]
- Ho, Y.-S. Review of second-order models for adsorption systems. J. Hazard. Mater. 2006, 136, 681–689. [Google Scholar] [CrossRef]
- Rahman Bhuiyan, M.A.; Hossain, M.A.; Zakaria, M.; Islam, M.N.; Zulhash Uddin, M. Chitosan coated cotton fiber: Physical and antimicrobial properties for apparel use. J. Polym. Environ. 2017, 25, 334–342. [Google Scholar] [CrossRef]
- Chung, C.; Lee, M.; Choe, E.K. Characterization of cotton fabric scouring by FT-IR ATR spectroscopy. Carbohydr. Polym. 2004, 58, 417–420. [Google Scholar] [CrossRef]
- Ciolacu, D.; Ciolacu, F.; Popa, V.I. Amorphous cellulose—Structure and characterization. Cellul. Chem. Technol. 2011, 45, 13. [Google Scholar]
- Chen, J.; Liao, W.; Jiang, Y.; Yu, D.; Zou, M.; Zhu, H.; Zhang, M.; Du, M. Facile fabrication of ZnO/TiO2 heterogeneous nanofibres and their photocatalytic behaviour and mechanism towards Rhodamine B. Nanomater. Nanotechnol. 2016, 6, 9. [Google Scholar] [CrossRef]
- Chaudhari, S.M.; Gawal, P.M.; Sane, P.K.; Sontakke, S.M.; Nemade, P.R. Solar light-assisted photocatalytic degradation of methylene blue with Mo/TiO2: A comparison with Cr-and Ni-doped TiO2. Res. Chem. Intermed. 2018, 44, 3115–3134. [Google Scholar] [CrossRef]
- Khade, G.V.; Gavade, N.L.; Suwarnkar, M.B.; Dhanavade, M.J.; Sonawane, K.D.; Garadkar, K.M. Enhanced photocatalytic activity of europium doped TiO2 under sunlight for the degradation of methyl orange. J. Mater. Sci. Mater. Electron. 2017, 28, 11002–11011. [Google Scholar] [CrossRef]
- Nadeem, N.; Abbas, Q.; Yaseen, M.; Jilani, A.; Zahid, M.; Iqbal, J.; Murtaza, A.; Janczarek, M.; Jesionowski, T. Coal fly ash-based copper ferrite nanocomposites as potential heterogeneous photocatalysts for wastewater remediation. Appl. Surf. Sci. 2021, 565, 150542. [Google Scholar] [CrossRef]
- Ashiq, H.; Nadeem, N.; Mansha, A.; Iqbal, J.; Yaseen, M.; Zahid, M.; Shahid, I. G-C3N4/Ag@ CoWO4: A novel sunlight active ternary nanocomposite for potential photocatalytic degradation of rhodamine B dye. J. Phys. Chem. Solids 2021, 161, 110437. [Google Scholar] [CrossRef]
- Nadeem, N.; Zahid, M.; Rehan, Z.A.; Hanif, M.A.; Yaseen, M. Improved photocatalytic degradation of dye using coal fly ash-based zinc ferrite (CFA/ZnFe2O4) composite. Int. J. Environ. Sci. Technol. 2021, 19, 3045–3060. [Google Scholar] [CrossRef]
- Lin, L.; Yang, Y.; Men, L.; Wang, X.; He, D.; Chai, Y.; Zhao, B.; Ghoshroy, S.; Tang, Q. A highly efficient TiO2@ ZnO n–p–n heterojunction nanorod photocatalyst. Nanoscale 2013, 5, 588–593. [Google Scholar] [CrossRef] [PubMed]
- Weon, S.; Kim, J.; Choi, W. Dual-components modified TiO2 with Pt and fluoride as deactivation-resistant photocatalyst for the degradation of volatile organic compound. Appl. Catal. B Environ. 2018, 220, 1–8. [Google Scholar] [CrossRef]
- Tabasum, A.; Alghuthaymi, M.; Qazi, U.Y.; Shahid, I.; Abbas, Q.; Javaid, R.; Nadeem, N.; Zahid, M. UV-Accelerated Photocatalytic Degradation of Pesticide over Magnetite and Cobalt Ferrite Decorated Graphene Oxide Composite. Plants 2021, 10, 6. [Google Scholar] [CrossRef]
- Ding, X. Fabric permeability testing. In Fabric Testing; Elsevier: Amsterdam, The Netherlands, 2008; pp. 189–227. [Google Scholar]
- Saville, B. Physical Testing of Textiles; Elsevier: Amsterdam, The Netherlands, 1999. [Google Scholar]
- Moiz, A.; Padhye, R.; Wang, X. Durable superomniphobic surface on cotton fabrics via coating of silicone rubber and fluoropolymers. Coatings 2018, 8, 104. [Google Scholar] [CrossRef]
- Zeng, C.; Wang, H.; Zhou, H.; Lin, T. Self-cleaning, superhydrophobic cotton fabrics with excellent washing durability, solvent resistance and chemical stability prepared from an SU-8 derived surface coating. RSC Adv. 2015, 5, 61044–61050. [Google Scholar] [CrossRef]
- Moiz, A.; Vijayan, A.; Padhye, R.; Wang, X. Chemical and water protective surface on cotton fabric by pad-knife-pad coating of WPU-PDMS-TMS. Cellulose 2016, 23, 3377–3388. [Google Scholar] [CrossRef]
- Karthik, T.; Senthilkumar, P.; Murugan, R. Analysis of comfort and moisture management properties of polyester/milkweed blended plated knitted fabrics for active wear applications. J. Ind. Text. 2018, 47, 897–920. [Google Scholar] [CrossRef]
- Shaid, A.; Wang, L.; Padhye, R.; Bhuyian, M.A.R. Aerogel nonwoven as reinforcement and batting material for firefighter’s protective clothing: A comparative study. J. Sol-Gel Sci. Technol. 2018, 87, 95–104. [Google Scholar] [CrossRef]
- Chen, Z.; Zhao, J.; Chen, J.; Zhang, Y.; Chen, D.; Wang, Q.; Xia, D. UiO-66/BiOBr heterojunction functionalized cotton fabrics as flexible photocatalyst for visible-light driven degradation of dyes and Cr(VI). Sep. Purif. Technol. 2021, 258, 118007. [Google Scholar] [CrossRef]
- Jahid, M.A.; Hu, J.; Wong, K.; Wu, Y.; Zhu, Y.; Sheng Luo, H.H.; Zhongmin, D. Fabric coated with shape memory polyurethane and its properties. Polymers 2018, 10, 681. [Google Scholar] [CrossRef]
- Wang, Y.; Yang, L.; Zou, R.; Lan, J.; Yao, A.; Xiao, H.; Lin, S. Z-scheme CeO2/Ag/CdS heterojunctions functionalized cotton fibers as highly recyclable and efficient visible light-driven photocatalysts for the degradation of dyes. J. Clean. Prod. 2022, 380, 135012. [Google Scholar] [CrossRef]

| Fabric Type | Dye | % Reduction | Fabric Type | Dye | % Reduction |
|---|---|---|---|---|---|
| C-Zn@TiO2(04) | MB | 95 | C-Zn@TiO2(08) | MB | 91 |
| MO | 97 | MO | 90 | ||
| Y | 67 | Y | 44 | ||
| R | 88 | R | 77 | ||
| NB | 93 | NB | 72 | ||
| C-Zn@TiO2(06) | MB | 90 | Uncoated | MB | 35 |
| MO | 89 | MO | 39 | ||
| Y | 35 | Y | 28 | ||
| R | 79 | R | 39 | ||
| NB | 72 | NB | 35 |
| Disperse Dyes | Fabric Type | |
|---|---|---|
| Uncoated | C-Zn@TiO2(4) | |
| Yellow | 39.25 | 88.73 |
| Orange | 11.18 | 70.5 |
| Red | 33.44 | 58.5 |
| Dye | 1st Order Kinetics | 2nd Order Kinetics | ||
|---|---|---|---|---|
| R2 | K1 (min−1) | R2 | K2 (L µmol−1min−1) | |
| MB | 0.90 | 0.0087 | 0.87 | 0.0006 |
| MO | 0.99 | 0.0131 | 0.91 | 0.0005 |
Disclaimer/Publisher’s Note: The statements, opinions and data contained in all publications are solely those of the individual author(s) and contributor(s) and not of MDPI and/or the editor(s). MDPI and/or the editor(s) disclaim responsibility for any injury to people or property resulting from any ideas, methods, instructions or products referred to in the content. |
© 2023 by the authors. Licensee MDPI, Basel, Switzerland. This article is an open access article distributed under the terms and conditions of the Creative Commons Attribution (CC BY) license (https://creativecommons.org/licenses/by/4.0/).
Share and Cite
Arfa, U.; Alshareef, M.; Nadeem, N.; Javid, A.; Nawab, Y.; Alshammari, K.F.; Zubair, U. Sunlight-Driven Photocatalytic Active Fabrics through Immobilization of Functionalized Doped Titania Nanoparticles. Polymers 2023, 15, 2775. https://doi.org/10.3390/polym15132775
Arfa U, Alshareef M, Nadeem N, Javid A, Nawab Y, Alshammari KF, Zubair U. Sunlight-Driven Photocatalytic Active Fabrics through Immobilization of Functionalized Doped Titania Nanoparticles. Polymers. 2023; 15(13):2775. https://doi.org/10.3390/polym15132775
Chicago/Turabian StyleArfa, Ume, Mubark Alshareef, Nimra Nadeem, Amjed Javid, Yasir Nawab, Khaled F. Alshammari, and Usman Zubair. 2023. "Sunlight-Driven Photocatalytic Active Fabrics through Immobilization of Functionalized Doped Titania Nanoparticles" Polymers 15, no. 13: 2775. https://doi.org/10.3390/polym15132775
APA StyleArfa, U., Alshareef, M., Nadeem, N., Javid, A., Nawab, Y., Alshammari, K. F., & Zubair, U. (2023). Sunlight-Driven Photocatalytic Active Fabrics through Immobilization of Functionalized Doped Titania Nanoparticles. Polymers, 15(13), 2775. https://doi.org/10.3390/polym15132775

